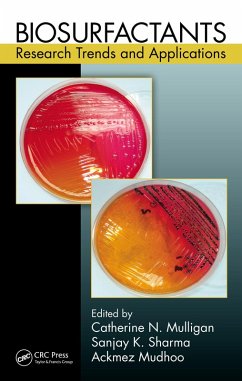

Guanghui Ma received her Bachelor's degree in polymer engineering at Gunma University, Gunma, Japan, in 1988. She obtained her MSc in 1990 and PhD degree in 1993 in polymer chemistry from Tokyo Institute of Technology, Japan. After a year as a research fellow at Tokyo Institute of Technology, she was appointed assistant professor in the Department of Chemical Engineering, Tokyo University of Agriculture and Technology, Japan, in 1994, and assistant professor in the Graduate School of Bio-Applications and Systems Engineering, Tokyo University of Agriculture and Technology in 1996. In 2001, she was appointed professor at the Institute of Process Engineering (IPE), Chinese Academy of Sciences, Beijing, China. Currently she is the vice president of IPE , director of the National Engineering Research Center for Biotechnology (Beijing), and editorial board member of Journal of Microencapsulation and Particuology. Prof. Ma's research interest includes biomaterials and bioformulations. Her expertise lies in the preparation of uniform-sized and structure-controllable microspheres and microcapsules for bioseparation media, controlled release carriers, enzyme immobilization and vaccine adjuvants, with 150 peer-reviewed papers in international journals, 6 English and 3 Chinese scientific books, and a number of book chapters. She also has more than 20 patents and collaborations with industry for technology applications. She received several awards in science and technology, including Science and Technology Prize 2005 of Beijing, National Technological Invention Prize 2009 of China, and Asian Regional Young Women Researcher Award 2009 from TWAS-TWOWS-SCOPUS. Professor Zhiguo Su received his bachelor's degree in chemical engineering from Dalian University of Technology (DUT), Dalian, China, in 1982 and PhD in biochemical engineering from the University of Manchester, England, in 1985. After a year as a postdoctoral fellow at Delft University of Technology, the Netherlands, in 1986, he became a lecturer of DUT in 1987, associate professor in 1988, and professor in 1991. He was a visiting scientist at the Massachusetts Institute of Technology, USA, in 1990 and 1992-1993. Currently he is the director of the National Key Laboratory of Biochemical Engineering and Professor at Institute of Process Engineering, Chinese Academy of Sciences, Beijing, China. Prof Su's research interest focuses on biomolecular and bioprocess engineering. He has been responsible for several major research projects on biopharmaceutical process technologies in China over the past few years, including production of hepatitis B vaccine, pegylated cytokines, and modified hemoglobin as blood substitutes. He has published more than 160 papers in international journals on protein refolding, modification and drug delivery. He was a committee member of a number of international conferences and serves as the editorial board member of Artificial Cells, Blood Substitutes and Biotechnology and Journal of Chemical Technology and Biotechnology and the associate editor of Chinese Journal of Biotechnology.